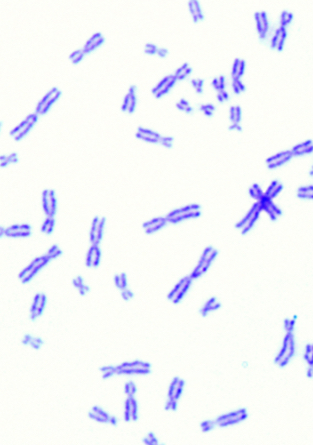
Mann behandelt

Geschlechter haben Einfluss auf die Symptome und Therapieansätze, trotzdem finden in der Humanmedizin ihre biologischen Unterschiede immer noch wenig Beachtung. Diesem Misstand liegt die Tatsache zugrunde, dass Forschung viel zu lange nur an Männern betrieben wurde. Ihre Anatomie wurde so zum Standard in der Medizin. Das führt zu fehlgedeuteten Symptomen und wenig effektiven Therapieansätzen mit fatalen Folgen.
Man[n] behandelt
Ein neuer Blick auf Medizin

Kann
überraschen



